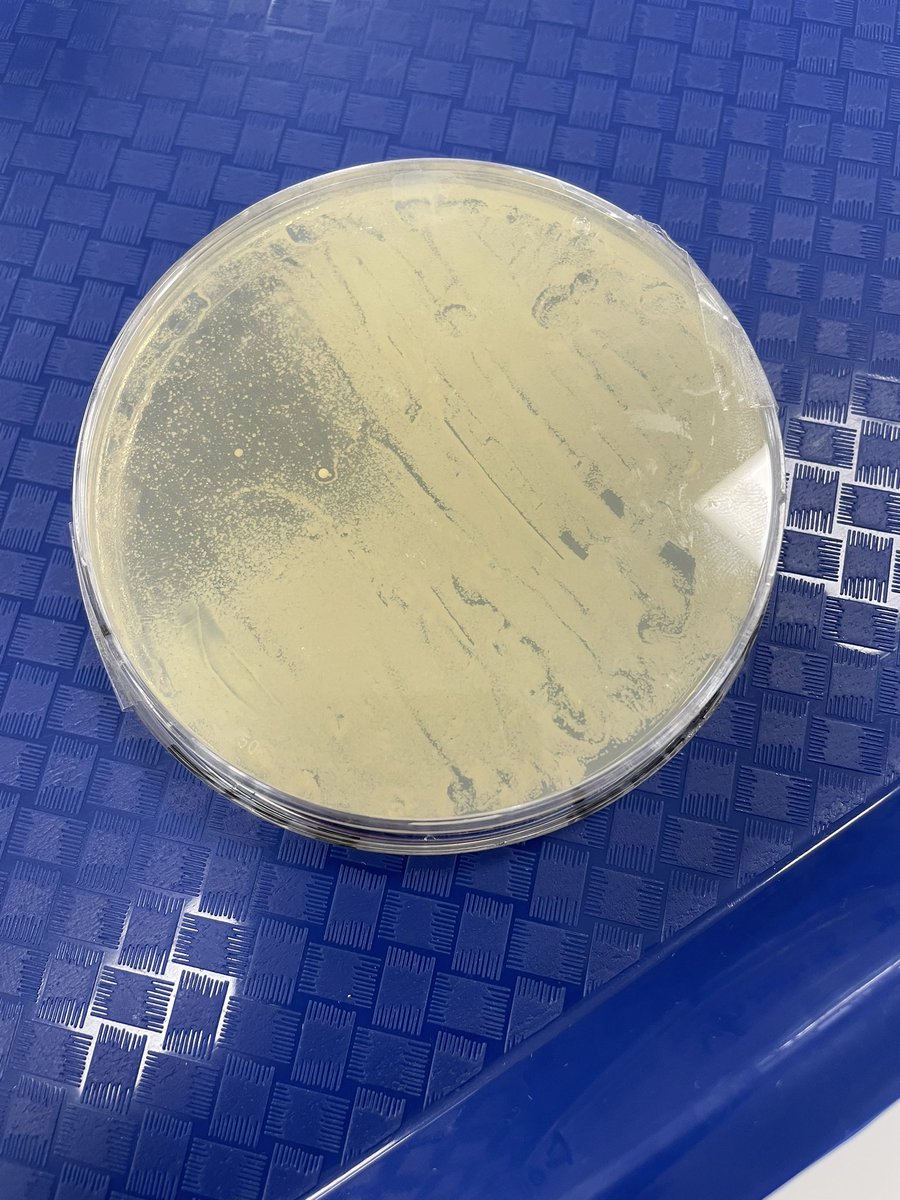
Claire tweet media

Claire
4.1K posts


Claire
@bear48
Secondary Science Teacher in Melbourne, Australia. Opinions are my own.
Melbourne, Australia Katılım Şubat 2009
405 Takip Edilen404 Takipçiler

@KJF239 @EastLeakeAC Thank you! I’m not familiar with that one! Will have to add it to my “to try” list!
English

@bear48 @EastLeakeAC It’s DCPIP with leaf extract. Different wavelengths of light by using the coloured filters. Time how long it takes to decolourise as the DCPIP gets reduced
English


@EndMyki I’ve known about this for a while.
There is a tour that runs from the environment office in Inverloch.
dinosaurdreaming.monash.edu
English

@TeacherMelb YOU HAVE A TWIN?!!!
I feel like maybe I knew that but had completely forgotten 🤔
English

@jodyflawson Was quite straight forward. Got to introduce agar plates and streaking to Y9s. Needed about an hour exposed to sunlight. Yeast from Southern Biological. Cheaper for lab techs to make up the cultures and agar compared with buying the kits.
English

@BeaulieuBio @MrsDrSarah Ooo. I wasn’t aware of that trick! Making a note for our kidney dissections later this term!
GIF
English

@MrsDrSarah Did the ol’ hydrogen peroxide trick, and those nephrons were stunning!
English

@bear48 How much running buffer are you using? We recommend sticking to 30-35 mL
English